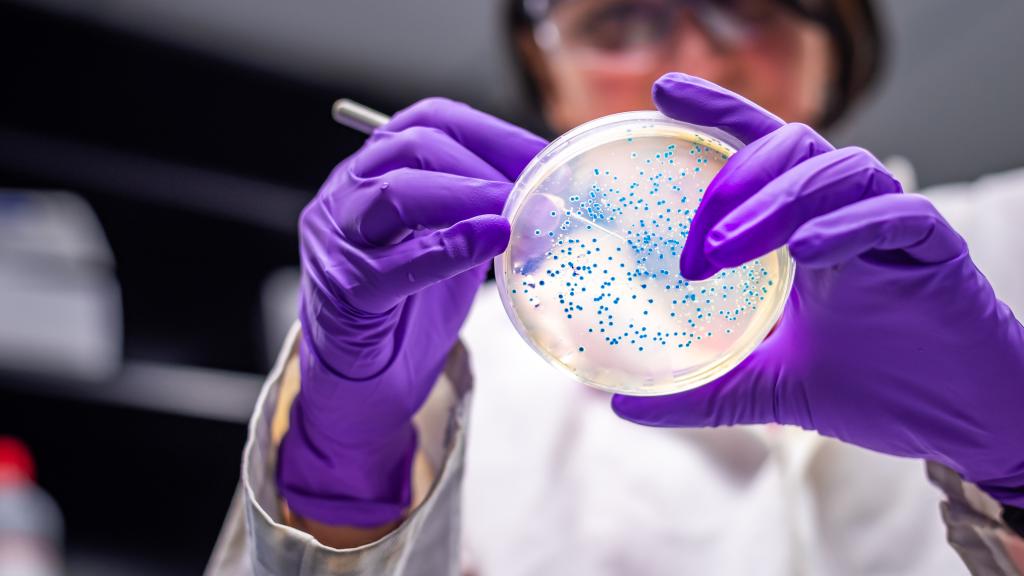
Resistencia a los antibióticos.

Resistencia a los antibióticos. iStock
La resistencia a los antibióticos ya causa más muertes al año que el SIDA o la malaria
El mayor análisis realizado hasta la fecha revela que las superbacterias provocaron 1,27 millones de decesos en 2019.
Noticias relacionadas
El impacto generado por la Covid-19 ha provocado que otras amenazas potencialmente mortales hayan quedado olvidadas por los estragos causados por la pandemia. Es el caso de las superbacterias resistentes a los antibióticos. Por primera vez, el mayor análisis realizado hasta la fecha, que publica ahora The Lancet, recoge su impacto global y señala que en el año 2019 causó 1,27 millones de decesos. Más, incluso, que el SIDA o la malaria, con hasta 860.000 y 640.000 muertes en ese año, respectivamente
El estudio revela por tanto que, en base a los datos recopilados en 204 países, las superbacterias son una de las principales causas de muerte en todo el mundo. Infecciones comunes que antes eran tratables, y que están relacionadas con las vías respiratorias inferiores y el torrente sanguíneo, ahora provocan cientos de miles de fallecimientos. Las bacterias que las causan se han vuelto resistentes al tratamiento. O lo que es lo mismo, los microbios ya no responden a los antibióticos creados para eliminarlos.
Bruno González-Zorn, catedrático del Departamento de Sanidad Animal de la Facultad de Veterinaria de la Universidad Complutense de Madrid y asesor de la OMS, explica que las bacterias "son el ser vivo más exitoso de la Tierra". Se ha podido adaptar a todos los ecosistemas y al intestino de todos los animales del mundo. "Llevan 4.000 millones de años entrenándose y adaptándose para resistir a los antibióticos", cuenta.
Para conocer los datos, el informe Global Research on Antimicrobial Resistance (GRAM) ha utilizado modelos estadísticos para realizar estimaciones sobre el impacto de la resistencia a los antibióticos en el mundo en relación a 23 patógenos y 88 combinaciones de patógenos en 2019. En este sentido, analiza las muertes que no habrían ocurrido si las infecciones hubieran sido susceptibles a los medicamentos y, por lo tanto, más tratables, así como las muertes asociadas, es decir, cuando una infección resistente a los medicamentos está implicada en los fallecimientos, pero la resistencia en sí misma puede o no haber sido la causa directa.
Entre todos los patógenos, es especialmente reseñable la resistencia a dos clases de antibióticos que a menudo se consideran la defensa de primera línea contra infecciones graves. Entre ellos, las fluoroquinolonas y los antibióticos betalactámicos, que se relacionaron con más del 70% de las muertes.
Infecciones de las vías respiratorias inferiores como la neumonía tuvieron la mayor carga de morbilidad. Según los datos del GRAM, causó al menos 400.000 muertes y se asoció a 1,5 millones de decesos. Otras como la sepsis pueden deberse a la resistencia a medicamentos para infecciones del torrente sanguíneo. En total, esta fue la causa de unas 370.000 muertes en todo el mundo y, al menos, se relacionó con casi 1,5 millones de fallecimientos. Asimismo, la resistencia a los medicamentos en las infecciones intraabdominales, comúnmente causadas por apendicitis, causó unos 210.000 muertos y se asoció con alrededor de 800.000.
Chris Murray, coautor del estudio y profesor del Instituto de Métricas y Evaluación de la Salud de la Universidad de Washington, asegura que estos datos son una señal clara de la necesidad de actuar ahora para combatir esta amenaza para la salud. El experto explica que las estimaciones anteriores habían pronosticado 10 millones de muertes anuales por la resistencia a los antimicrobianos para 2050. Sin embargo, apunta que "ahora sabemos con certeza que ya estamos mucho más cerca de esa cifra de lo que pensábamos".
La farmacorresistencia afecta a personas de todas las edades, pero, según apunta el análisis, los niños son los más vulnerables. Los más pequeños corren un riesgo particularmente alto, con alrededor de una de cada cinco muertes atribuibles a la resistencia a los antibióticos en menores de cinco años.
El estudio señala además zonas más vulnerables que otras a las superbacterias. En concreto, se ha estimado que las muertes causadas directamente por la resistencia a los antimicrobianos eran más altas en el África subsahariana y el sur de Asia, con 24 muertes y 22 muertes por cada 100.000 habitantes, respectivamente.
No obstante, como explica González-Zorn, cuando hablamos de resistencia a los antibióticos uno de los mayores problemas es cuantificar la mortalidad relacionada. Entre otros motivos, el doctor señala que "estas muertes no están producidas por una sola bacteria ni por un tipo de infección, y por ello, a los pacientes que fallecen por esto, se les llama anónimos". Pueden deberse a la resistencia a diferentes patógenos que pueden originarse por una infección postquirúrgica, una infección respiratoria intratable o un neumococo resistente a la penicilina. "Son bacterias distintas e infecciones distintas", indica González.
Los autores, además, reconocen algunas limitaciones en su estudio. Entre otras cosas, la disponibilidad limitada de datos para algunas partes del mundo -en particular, de muchos países de ingresos bajos y medianos- puede limitar la precisión de las estimaciones en estos lugares, donde se requirieron fuertes suposiciones metodológicas para el análisis.
Los antibióticos en la era covid
La resistencia de estas bacterias ya es un problema de salud pública. Para González-Zorn, "es una pandemia silenciosa" de la que es importante hacerse eco, no sólo para que se prescriba mejor, sino para que los que los consuman también mejoren en su utilización. "De esto, en España, tenemos margen de mejora", reconoce González. La automedicación, su mal reciclaje, por ejemplo, empeoran aún más la situación con respecto a las superbacterias.
En España, según datos del último Plan Nacional frente a la Resistencia a los Antibióticos (PRAN), el consumo de antibióticos decrece cada año. Aún así, en el ránking europeo, nuestro país se coloca el 5º en el ámbito comunitario y el 14ª en hospitales. En muchas ocasiones, el uso excesivo o inadecuado de estos tratamientos provoca una fuerte resistencia. Tanto que se calcula que, cada año, llegan a fallecer en España unas 3.000 personas por este motivo.
La pandemia de la Covid-19, lejos de ayudar, ha potenciado aún más este peligro. La tendencia decreciente en el consumo de antibióticos se rompió con la primera ola del coronavirus en marzo de 2020. De acuerdo al PRAN, por estas fechas se produjo "una importante subida", en torno al 40%, del uso de estos tratamientos en los hospitales como consecuencia de la incertidumbre diagnóstica.
La propia Organización Mundial de la Salud (OMS) advirtió en ese mismo año que el abuso de los antibióticos durante la pandemia iba a incrementar el desarrollo de bacterias resistentes a futuros tratamientos y, con ello, el número de muertes provocadas por este problema de salud pública.
Una investigación reciente, basada en datos del Registro SEMI-Covid-19 de la Sociedad Española de Medicina Interna (SEMI), analizó además el uso de antimicrobianos en pacientes españoles hospitalizados por coronavirus y constató que su uso ha sido generalizado. Sobre todo, durante la primera fase de la pandemia, cuando se utilizaron antibióticos en el 79,5% de los casos. Además, se concluyó que, al menos, un 34% de los pacientes estudiados recibieron antibioterapia de forma inadecuada.
En esta última ola de coronavirus, indica González, se está observando que al haber más pacientes ingresados en UCI’s -sobre todo en países donde las condiciones higiénico-sanitarias son menores-, se está incrementando el uso de antibióticos. "El uso inadecuado es la fuerza motriz principal [de la resistencia], y por eso hay que reducirlos", asegura González, que señala que en el mundo al menos un tercio de los antibióticos se prescriben inadecuadamente.
Por este motivo, el último informe publicado en The Lancet advierte de la necesidad urgente de aumentar la acción para combatir la farmacorresistencia y describe acciones inmediatas para los formuladores de políticas que ayudarán a salvar vidas y proteger los sistemas de salud. Entre ellos está el hecho de optimizar el uso de los antibióticos existentes, tomar más medidas para monitorear y controlar las infecciones y proporcionar más fondos para desarrollar nuevos antibióticos y tratamientos.
Para los autores, el gasto debe dirigirse a la prevención de infecciones en primer lugar, asegurándose de que los antibióticos existentes se utilicen de manera adecuada y juiciosa, y a llevar nuevos antibióticos al mercado. Además, los líderes políticos y de salud deben tomar medidas seriamente para abordar la resistencia a los antimicrobianos y el desafío del acceso deficiente a antibióticos efectivos y asequibles.
A nivel mundial, existen varias estrategias que se están llevando a cabo. Como apunta González-Zorn, es la de cooperar entre diferentes profesiones. Es decir, se trabaja desde una perspectiva de One Health, o una única salud, en la que se combatan las mismas patologías en salud humana y sanidad animal, ayudando a prevenir así futuras pandemias.




